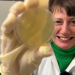
Bild 6

Ganz Ohr
Warum werden wir leichter krank? (Österreich)
Im Bild: Kinderärztin Veronika erklärt, welchen Einfluss die Jahreszeit auf Viren hat.
Bildauswahl:

Im Bild: Kinderärztin Veronika erklärt, welchen Einfluss die Jahreszeit auf Viren hat.

Im Bild: Esther und Miranda fragen sich, auf welcher Oberfläche sie wohl am meisten Keime finden werden.

Im Bild: Signation.

Im Bild: Veronika zeigt Esther, wie eine Untersuchung in ihrer Praxis stattfindet.

Im Bild: Veronika zeigt Esther, wie eine Untersuchung in ihrer Praxis stattfindet.
Im Bild: Esther hat versucht, die Keime am Klo einzufangen.

Im Bild: Nach 24 Stunden bei 37 Grad im Brutschrank vermehren sich die Bakterien, dann kann man sie sogar mit bloßem Auge sehen.

Im Bild: Miranda ist Hygienikerin und versucht herauszufinden, wo überall Bakterien und Pilze drauf sind.

